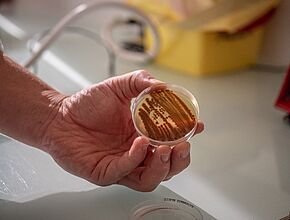
Agrandir l'image (fenêtre modale)

Public Labos, Laboratoire vétérinaire, eaux et sols
Dans les coulisses de Public Labos, laboratoire vétérinaire, eaux et sols
L’union fait la force. Le laboratoire vétérinaire eaux et sols du Gers a fusionné en 2020 au sein d’une entité interdépartementale, rebaptisée « Public Labos », qui regroupe les laboratoires d’analyses départementaux du Gers, du Lot et du Tarn. Une alliance de compétences pointues au service d’une mission commune : garantir la santé publique et préserver notre environnement. Le laboratoire du Gers nous a ouvert ses portes.
L’eau que vous buvez, les aliments que vous consommez, la terre que vous travaillez, l’air que vous respirez… c’est à tout cela que veillent tout au long de l’année les 24 agents du site gersois de Public Labos, qui mutualise depuis 2020 ses moyens avec les laboratoires du Tarn et du Lot.
« Nous avons une mission première de service public et développons des projets adaptés au territoire, qui font sens pour la collectivité », précise Emmanuel Esposito, directeur de Public Labos, « nous intervenons sur trois secteurs d’activité : la santé animale, la sécurité et l’hygiène alimentaire et la protection des eaux et de l’environnement. Nous avons un rôle de conseil et assurons également des audits et des formations ».
Au 824 chemin de Nareoux, à Auch, les blouses blanches vont et viennent dans les couloirs de l’imposant bâtiment de 1000 m2, qui abrite depuis 2001 le laboratoire départemental du Gers. L’activité, même en plein été, ne s’arrête jamais. Dans les différentes unités dédiées aux secteurs d’activité de Public Labos, les analyses s’enchaînent. Les yeux rivés sur leurs microscopes, les techniciens de laboratoire observent les micro-organismes à la loupe, traquent sans relâche les polluants, bactéries, virus et autres parasites.
Ils analysent plusieurs centaines d’échantillons par jour, déposés par les préleveurs du laboratoire ou directement par des entreprises, des industriels de l’agro-alimentaire, des agriculteurs ou encore des particuliers.
Un service de proximité
Public Labos oeuvre au service du Conseil départemental et de ses politiques publiques, il assure le suivi des programmes imposés par l’État, travaille pour le compte des collectivités locales et de l’Agence Régionale de Santé, mais il peut également intervenir pour des privés. Vous souhaitez connaître la qualité de l’eau de votre piscine ? Le labo peut l’analyser. Vous voulez déterminer les qualités physicochimiques de votre sol ? Une unité de Public Labos est spécialement dédiée à l’agronomie. Vous avez un doute sur la santé de vos animaux ? Les vétérinaires départementaux interviennent sur vos cheptels... « Il est important de conserver ces centres de compétences que sont les laboratoires départementaux en milieu rural, ils permettent d’assurer un accès local et un service de proximité », estime Emmanuel Esposito.



Sécurité alimentaire dans les cantines, contrôle de l’air dans les établissements scolaires, surveillance de la qualité des sols, de l’eau potable, des eaux de rivière, contrôle des stations d’épuration et des eaux usées, veille épidémiologique, lutte anti-vectorielle, interventions sur le terrain, actions de formation et de sensibilisation… Public Labos est sur tous les fronts pour veiller à la sécurité sanitaire et environnementale du territoire.
Des moustiques tigres sous haute surveillance

Public Labos du Gers mène une mission de lutte anti-vectorielle pour l’Agence Régionale de Santé afin de prévenir la propagation du moustique tigre (Aedes albopictus). Le laboratoire étudie les populations de moustiques et forme les collectivités aux bonnes pratiques de prévention de leur développement. Il intervient également pour traiter l’environnement d’une personne ayant contracté une maladie (chikungunya, dengue, zika…) véhiculée par le moustique tigre.
En chiffres :
170 000 analyses réalissés par Public Labos Gers en 2022 toutes unités confondues
Le saviez-vous ?
Public Labos est doté d’une unité dédiée aux autopsies animales dans le but de prélever des échantillons et de rechercher des parasites et des bactéries. En 2022, les techniciens du laboratoire ont effectué 182 autopsies animales et effectué près de 3 500 analyses bactériologiques et parasitaires.